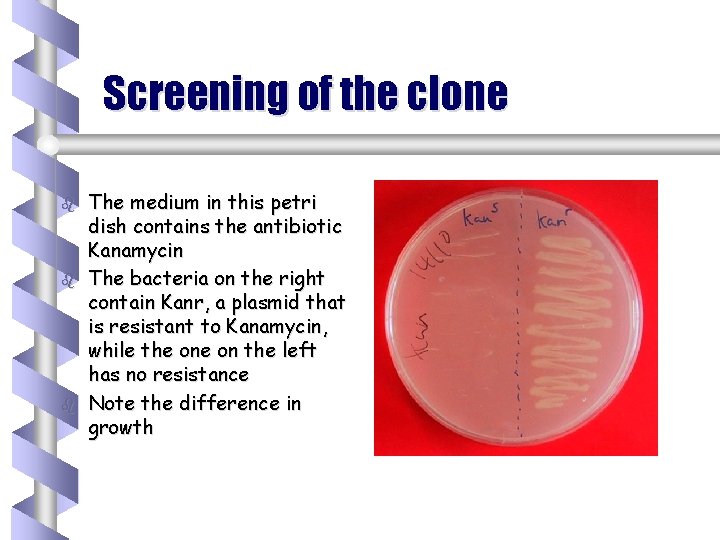
Screening of the clone b b b The medium in this petri dish contains

Cutting DNA b Restriction endonucleases restriction enzymes sticky

Cutting DNA b Restriction endonucleases (restriction enzymes) • sticky ends • blunt ends b Nomenclature • • • Eco. RI E = genus (Escherichia) co = species (coli) R = strain I = # of enzyme

Blunt & Sticky ends

Pasting DNA b Complementary ends (sticky ends) H-bond b Ligase forms phosphodiester bond to seal strands together.

A plasmid vector for cloning 1. Contains an origin of replication, allowing for replication independent of host’s genome. 2. Contains Selective markers: Selection of cells containing a plasmid twin antibiotic resistance blue-white screening 3. Contains a multiple cloning site (MCS) 4. Easy to be isolated from the host cell.

Plasmid vectors

Expression vector

How to clone DNA b b b Isolation of cloning vector (bacterial plasmid) & genesource DNA (gene of interest) Insertion of gene-source DNA into the cloning vector using the same restriction enzyme; bind the fragmented DNA with DNA ligase Introduction of cloning vector into cells (transformation by bacterial cells) Cloning of cells (and foreign genes) Identification of cell clones carrying the gene of interest
Screening of the clone b b b The medium in this petri dish contains the antibiotic Kanamycin The bacteria on the right contain Kanr, a plasmid that is resistant to Kanamycin, while the on the left has no resistance Note the difference in growth

Blue/White Color Screening lac. Z functional enzyme X-gal product insert nonfunctional enzyme X-gal product

Selecting Colonies with Recombinant Plasmids
- Slides: 10